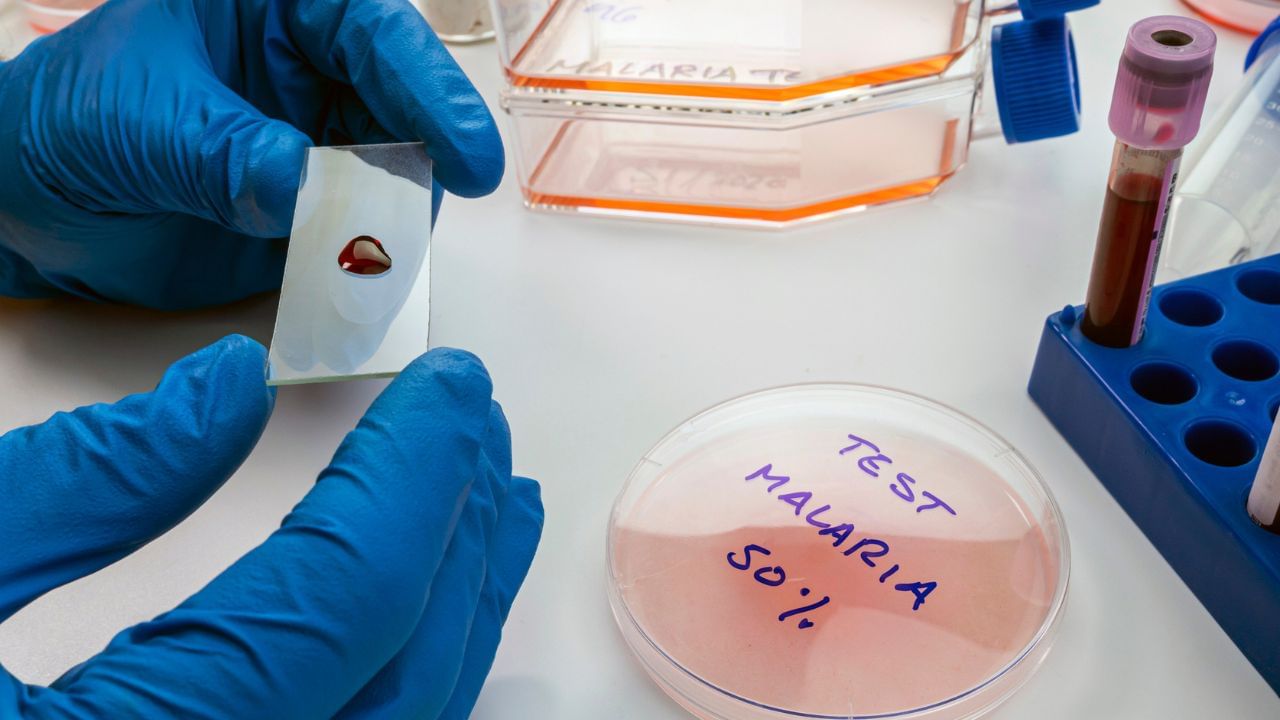
ಮಲೇರಿಯಾ ಸೋಂಕನ್ನು ತಡೆಯಲು ಬಂತು ಮೊದಲ ಲಸಿಕೆ! ಮಹಾಮಾರಿ ರೋಗದ ವಿರುದ್ಧ ಮಹತ್ವದ ಹೆಜ್ಜೆ

ಮಲೇರಿಯಾ ಸೋಂಕನ್ನು ತಡೆಯಲು ಬಂತು ಮೊದಲ ಲಸಿಕೆ! ಮಹಾಮಾರಿ ರೋಗದ ವಿರುದ್ಧ ಮಹತ್ವದ ಹೆಜ್ಜೆ
ಇನ್ನು ಮುಂದೆ ಮಲೇರಿಯಾ ಎಂಬ ಮಹಾಮಾರಿ ಕಾಯಿಲೆಗೆ ಹೆದರುವ ಅವಶ್ಯಕತೆ ಇಲ್ಲ. ಏಕೆಂದರೆ ನಮ್ಮ ದೇಶ ಇದರ ವಿರುದ್ಧ ಮಹತ್ವದ ಹೆಜ್ಜೆ ಇಟ್ಟಿದೆ. ಭಾರತೀಯ ವೈದ್ಯಕೀಯ ಸಂಶೋಧನಾ ಮಂಡಳಿ (ICMR) ಮಲೇರಿಯಾ ರೋಗವನ್ನು ತಡೆಯಲು ದೇಶದ ಮೊದಲ ಆಡ್ಫಾಲ್ಸಿವ್ಯಾಕ್ಸ್ ಎಂಬ ಲಸಿಕೆಯನ್ನು ಕಂಡು ಹಿಡಿದಿದೆ. ಹಾಗಾದರೆ ಈ ಲಸಿಕೆ ಹೇಗೆ ಕಾರ್ಯನಿರ್ವಹಿಸುತ್ತದೆ? ಇದರ ವಿಶೇಷತೆಗಳೇನು? ಎಲ್ಲಾ ಮಾಹಿತಿಯನ್ನು ಈ ಸ್ಟೋರಿ ಮೂಲಕ ತಿಳಿದುಕೊಳ್ಳಿ.
ಭಾರತದಲ್ಲಿ ಮಲೇರಿಯಾ (Malaria) ಒಂದು ಗಂಭೀರ ಕಾಯಿಲೆಯಾಗಿದ್ದು, ಪ್ರತಿ ವರ್ಷ ಲಕ್ಷಾಂತರ ಜನರನ್ನು ಬಾಧಿಸುತ್ತದೆ. ವಿಶೇಷವಾಗಿ ಮಳೆಗಾಲದಲ್ಲಿ ಸೊಳ್ಳೆಗಳ ಸಂಖ್ಯೆ ಹೆಚ್ಚಾದಾಗ, ಈ ರೋಗವು ಇನ್ನಷ್ಟು ಹರಡುತ್ತದೆ. ಆದರೆ ಈಗ ನಾವು ಈ ಮಹಾಮಾರಿಗೆ ಹೆದರುವ ಅವಶ್ಯಕತೆ ಇಲ್ಲ. ಏಕೆಂದರೆ ಭಾರತ ಈಗ ಮಲೇರಿಯಾ ವಿರುದ್ಧ ಮಹತ್ವದ ಹೆಜ್ಜೆ ಇಟ್ಟಿದೆ. ಭಾರತೀಯ ವೈದ್ಯಕೀಯ ಸಂಶೋಧನಾ ಮಂಡಳಿ (ICMR) ದೇಶದ ಮೊದಲ ಮಲೇರಿಯಾ ಲಸಿಕೆ ‘ಆಡ್ಫಾಲ್ಸಿವಾಕ್ಸ್’ (AdFalciVax) ಅನ್ನು ಕಂಡು ಹಿಡಿದಿದೆ. ಈ ಲಸಿಕೆ ಮಲೇರಿಯಾ ಸೋಂಕುಗಳಲ್ಲಿ ಅತ್ಯಂತ ಮಾರಕ ಎಂದು ಪರಿಗಣಿಸಲಾಗಿರುವ ಪ್ಲಾಸ್ಮೋಡಿಯಂ ಫಾಲ್ಸಿಪ್ಯಾರಮ್ ಅನ್ನು ನಾಶಪಡಿಸುವ ಮೂಲಕ ಮಲೇರಿಯಾ ಬರದಂತೆ ತಡೆಯುತ್ತದೆ. ಹಾಗಾದರೆ ಈ ಲಸಿಕೆ ಹೇಗೆ ಕಾರ್ಯನಿರ್ವಹಿಸುತ್ತದೆ? ಇದರ ವಿಶೇಷತೆಗಳೇನು ತಿಳಿದುಕೊಳ್ಳಿ.
ಈ ಲಸಿಕೆ ಹೇಗೆ ಕಾರ್ಯ ನಿರ್ವಹಿಸುತ್ತದೆ?
ಆಡ್ಫಾಲ್ಸಿವಾಕ್ಸ್ (AdFalciVax) ಎಂಬುದು ಮಲೇರಿಯಾ ಸೋಂಕು ನಮ್ಮ ದೇಹವನ್ನು ಪ್ರವೇಶಿಸುವುದನ್ನು ತಡೆಯುವ ಲಸಿಕೆಯಾಗಿದೆ. ಹೆಚ್ಚುವರಿಯಾಗಿ, ಈ ಲಸಿಕೆಯು ನಮ್ಮ ದೇಹವನ್ನು ರಕ್ಷಿಸುವುದಲ್ಲದೆ ಮಲೇರಿಯಾ ಹರಡುವುದನ್ನು ತಪ್ಪಿಸುತ್ತದೆ. ಮಾತ್ರವಲ್ಲ ಮಲೇರಿಯಾ ಮತ್ತೆ ದೇಹವನ್ನು ಪ್ರವೇಶಿಸುವುದನ್ನು ತಡೆಯುವ ಒಂದು ರೀತಿಯ ರೋಗನಿರೋಧಕ ಶಕ್ತಿಯನ್ನು ದೇಹದಲ್ಲಿ ಸೃಷ್ಟಿಸಲು ಇದನ್ನು ವಿನ್ಯಾಸಗೊಳಿಸಲಾಗಿದೆ.
ಲಸಿಕೆಯ ವಿಶೇಷತೆಗಳು;
ಈ ಲಸಿಕೆಯನ್ನು ಸಂಪೂರ್ಣವಾಗಿ ಭಾರತದಲ್ಲಿಯೇ ತಯಾರಿಸಲಾಗಿದ್ದು ‘ಮೇಕ್ ಇನ್ ಇಂಡಿಯಾ’ ಉಪಕ್ರಮದ ಒಂದು ಭಾಗವಾಗಿದೆ. ಇದರರ್ಥ ಭಾರತವು ಇನ್ನು ಮುಂದೆ ಮಲೇರಿಯಾ ಲಸಿಕೆಗಾಗಿ ವಿದೇಶಗಳನ್ನು ಅವಲಂಬಿಸುವುದಿಲ್ಲ ಬದಲಾಗಿ ನಮ್ಮ ದೇಶದಲ್ಲೇ ಅದನ್ನು ತಯಾರಿಸಿ ಎಷ್ಟು ಪ್ರಮಾಣದಲ್ಲಿ ಬೇಕಾದರೂ ಅದು ಲಭ್ಯವಿರುವಂತೆ ನೋಡಿಕೊಳ್ಳುತ್ತದೆ. ಆಡ್ಫಾಲ್ಸಿವಾಕ್ಸ್ ಲಸಿಕೆ ಭಾರತದಲ್ಲಿ ಮಲೇರಿಯಾ ತಡೆಗಟ್ಟುವಿಕೆ ಮತ್ತು ನಿರ್ಮೂಲನೆಗೆ ಸಹಾಯ ಮಾಡುತ್ತದೆ ಎಂದು ನಿರೀಕ್ಷಿಸಲಾಗಿದೆ. ಇದು ದೊಡ್ಡ ಪ್ರಮಾಣದಲ್ಲಿ ಯಶಸ್ವಿಯಾದರೆ, ಜಾಗತಿಕ ಮಟ್ಟದಲ್ಲಿ ಭಾರತದ ಪ್ರಮುಖ ವೈಜ್ಞಾನಿಕ ಸಾಧನೆ ಎಂದೇ ಪರಿಗಣಿಸಲಾಗುತ್ತದೆ. ಈ ಲಸಿಕೆಯ ಪೂರ್ವ- ಕ್ಲಿನಿಕಲ್ ಹಂತದ ಪರೀಕ್ಷೆ ಪೂರ್ಣಗೊಂಡಿದ್ದು ಸಕಾರಾತ್ಮಕ ಫಲಿತಾಂಶ ಕಂಡುಬಂದಿವೆ. ಇದನ್ನು ಈಗ ಮಾನವರ ಮೇಲಿನ ಪ್ರಯೋಗಗಳಿಗಾಗಿ ಕ್ಲಿನಿಕಲ್ ಹಂತಕ್ಕೆ ಸ್ಥಳಾಂತರಿಸಲಾಗುತ್ತಿದೆ. ಈ ಹಂತವು ಸುಮಾರು ಎರಡು ವರ್ಷಗಳ ಕಾಲ ಇರುತ್ತದೆ. ಯಶಸ್ವಿಯಾದರೆ, ಈ ಲಸಿಕೆ ದೇಶಾದ್ಯಂತ ಮಲೇರಿಯಾ ನಿರ್ಮೂಲನೆಗೆ ಒಂದು ಪ್ರಮುಖ ಅಸ್ತ್ರವಾಗಬಹುದು. ಐಸಿಎಂಆರ್ ಮತ್ತು ಇತರ ಆರೋಗ್ಯ ಸಂಸ್ಥೆಗಳು ಇದನ್ನು ಸಾಧ್ಯವಾದಷ್ಟು ಬೇಗ ಜನರಿಗೆ ಲಭ್ಯವಾಗುವಂತೆ ಮಾಡಲು ನಿರಂತರವಾಗಿ ಕೆಲಸ ಮಾಡುತ್ತಿವೆ.
ಇದನ್ನೂ ಓದಿ: ಬೆಂಗಳೂರು: ಹೆಚ್ಚಾಯ್ತು ಡೆಂಗ್ಯೂ, ಮನೆ ಬಳಿ ಸ್ವಚ್ಛತೆ ಕಾಪಾಡದಿದ್ದರೆ ಬೀಳಲಿದೆ ಭಾರೀ ಮೊತ್ತದ ದಂಡ
ಮಲೇರಿಯಾ ರೋಗವನ್ನು ನಿಯಂತ್ರಿಸುವುದು ಕಷ್ಟವಾಗುತ್ತಿರುವುದಕ್ಕೆ ಕಾರಣವೇನು?
ಸಾಂಕ್ರಾಮಿಕ ರೋಗಶಾಸ್ತ್ರಜ್ಞ ಡಾ. ಜುಗಲ್ ಕಿಶೋರ್ ಅವರು ನೀಡಿರುವ ಮಾಹಿತಿ ಪ್ರಕಾರ, ಭಾರತದ ಅನೇಕ ಭಾಗಗಳಲ್ಲಿ, ಅದರಲ್ಲಿಯೂ ವಿಶೇಷವಾಗಿ ಗ್ರಾಮೀಣ ಮತ್ತು ಬುಡಕಟ್ಟು ಪ್ರದೇಶಗಳಲ್ಲಿ, ಮಲೇರಿಯಾ ಇನ್ನೂ ಅಪಾಯಕಾರಿ ಕಾಯಿಲೆಯಾಗಿದೆ. ವಿಶ್ವ ಆರೋಗ್ಯ ಸಂಸ್ಥೆ (WHO) ಪ್ರಕಾರ, ಇತ್ತೀಚಿನ ವರ್ಷಗಳಲ್ಲಿ ಭಾರತದಲ್ಲಿ ಮಲೇರಿಯಾ ಪ್ರಕರಣಗಳ ಸಂಖ್ಯೆ ಕಡಿಮೆಯಾಗಿದ್ದರೂ, ಪ್ರತಿ ವರ್ಷ ಸಾವಿರಾರು ಸಂಖ್ಯೆಯಲ್ಲಿ ಸಾವುಗಳು ಸಂಭವಿಸುತ್ತಿವೆ. ಪ್ಲಾಸ್ಮೋಡಿಯಂ ಫಾಲ್ಸಿಪ್ಯಾರಮ್ ವಿಧದ ಮಲೇರಿಯಾ ಅತ್ಯಂತ ತೀವ್ರವಾಗಿದ್ದು ರಕ್ತ ಕಣಗಳು ಮತ್ತು ಅಂಗಗಳನ್ನು ತ್ವರಿತವಾಗಿ ಹಾನಿಗೊಳಿಸುತ್ತದೆ. ಅದಕ್ಕಾಗಿಯೇ ಈ ನಿರ್ದಿಷ್ಟ ವಿಧದ ಮಲೇರಿಯಾಕ್ಕೆ ಲಸಿಕೆಯನ್ನು ಕಂಡು ಹಿಡಿದಿರುವುದು ಗಮನಾರ್ಹ ಸಾಧನೆ ಎಂದು ಪರಿಗಣಿಸಲಾಗಿದೆ.
ಆರೋಗ್ಯ ಸುದ್ದಿಗಳನ್ನು ಓದಲು ಇಲ್ಲಿ ಕ್ಲಿಕ್ ಮಾಡಿ








